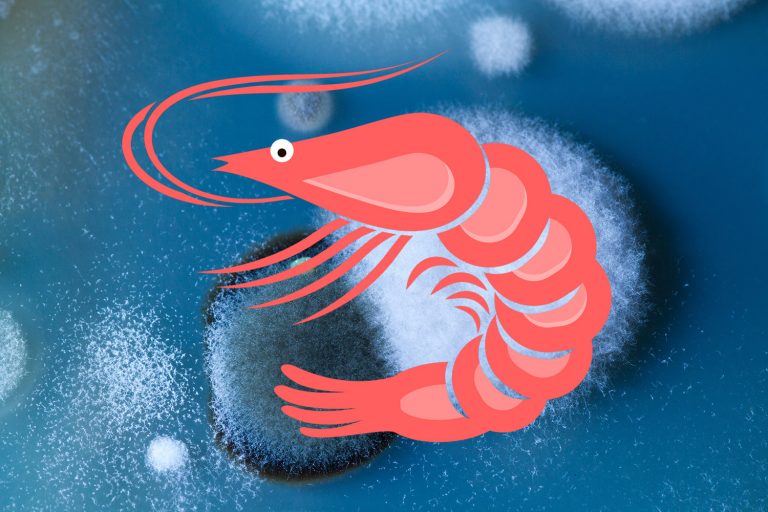
普维动物保健品有限公司, 动物饲料添加剂, 植物提取物, 植物生物素, 精油, PFA, 植物性饲料添加剂, 植物学, 植物性饲料添加剂, 新型促生长剂, 植物素, 替代抗生素促生长剂, 天然产品, 肠道健康, PlusVet Animal Health，养鸡，普维生，普乐壮，饲料添加剂，无抗养殖，植物提取物替代抗生素，

普霉克© Tag
- All
- 公司
- 反刍动物
- 宠物粮
- 家兔
- 水产动物
- 猪
- 肉鸡
- 蛋鸡和种鸡
- 霉菌毒素
- 鸭和鹅
重磅推荐!腺胃和肌胃糜烂的七大病因
10 October, 2018
蛋品质差?生产力低?青岛普维动保隆重推出芬乐多©(PhytoMax©),蛋鸡和种鸡的全新高端解决方案!
09 July, 2018
领先鸡©视频发布!
06 March, 2018
2017年中国饲料霉菌毒素污染统计报告
26 February, 2018
霉菌毒素对蛋鸡的毒性
16 January, 2018
新生仔猪霉菌毒素中毒的症状
15 January, 2018
近期使用普霉克和普维生+预防腺胃炎的成功案例
03 September, 2017
虾感染霉菌毒素的风险
14 July, 2017
霉菌毒素对鸭的毒性
07 June, 2017
Loading new posts...
No more posts